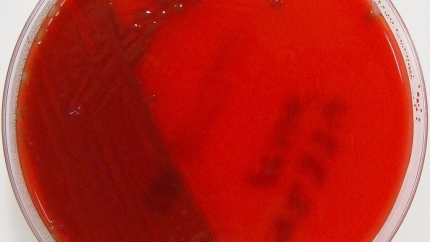
(Foto de ARCHIVO)Meningitis01/6/2017

Muere una niña de 5 años por meningitis en Huelva: una pediatra explica qué es y cómo prevenir la enfermedad
El fallecimiento de una menor en Villablanca (Huelva) por un cuadro fulminante pone el foco en los síntomas de esta grave enfermedad y en la importancia de las vacunas

(Foto de ARCHIVO)Los pediatras piden que la vacuna de la meningitis B sea financiada o haya ayudas para familias con pocos recursos11/1/2018
Huelva - Publicado el
2 min lectura0:32 min escucha
El triste fallecimiento de una niña de 5 años en Villablanca (Huelva) por un cuadro fulminante de meningitis ha puesto el foco sobre esta grave enfermedad. Para entender en qué consiste, cómo se contagia y, sobre todo, cómo se previene, la pediatra onubense María Ángeles Ganga ha explicado en el programa 'Herrera en Cope' las claves de esta patología.
¿Qué es la meningitis y cuáles son sus síntomas?
La meningitis es una inflamación de las meninges, las capas que protegen el cerebro y la médula espinal. Según la experta, esta inflamación "puede generar síntomas que pueden complicarse y ser muy graves".
Los síntomas que alertan de la enfermedad son "bastante evidentes y fuertes", e incluyen fiebre muy elevada, dolor de cabeza, rigidez de nuca y signos de tipo neurológico como la desorientación o la desconexión del paciente.
Grupos de riesgo y vías de contagio
Aunque puede afectar a toda la población, existen dos grupos más sensibles: los niños hasta la adolescencia y las personas ancianas. El contagio se produce por contacto estrecho y cercano de persona a persona, a través de gotas de saliva.
Gracias a todos los avances y al compromiso social y de la sanidad, cada vez vemos menos casos"
A pesar de la gravedad, la pediatra ha querido lanzar un mensaje de tranquilidad, asegurando que los casos son poco frecuentes gracias a los avances médicos. "Gracias a todos los avances y al compromiso social y de la sanidad, cada vez vemos menos casos", ha afirmado Ganga, aunque ha insistido en la importancia de detectarlos a tiempo.
La vacunación, clave para la prevención
La herramienta más eficaz para la prevención es la vacunación. La doctora ha puesto en valor la "gran campaña de vacunación" que se realiza desde los centros de salud a partir de los dos meses de edad. Estas vacunas, dirigidas contra agentes como el meningococo y el neumococo, están cubiertas íntegramente por la Seguridad Social e incluidas en el calendario oficial.
No obstante, Ganga ha recordado que no siempre fue así. "Hasta hace moderado tiempo, no estaban incluidas", ha señalado, explicando que desde las consultas siempre se recomendó su compra, con un coste que rondaba los 70 o 100 euros, por el gran beneficio que suponía.
Nosotros desde sanidad no lo hemos olvidado. Queremos que la población tampoco lo olvide"
Además de las vacunas, la pediatra ha recordado la importancia de medidas de higiene que se hicieron comunes durante la pandemia y que siguen siendo vitales, también para prevenir la gripe. "Nosotros desde sanidad no lo hemos olvidado. Queremos que la población tampoco lo olvide", ha subrayado. Medidas tan sencillas como el lavado de manos, la ventilación de espacios cerrados o el uso de mascarilla si se tienen síntomas son fundamentales para proteger a los más vulnerables.
Este contenido ha sido creado por el equipo editorial con la asistencia de herramientas de IA.



